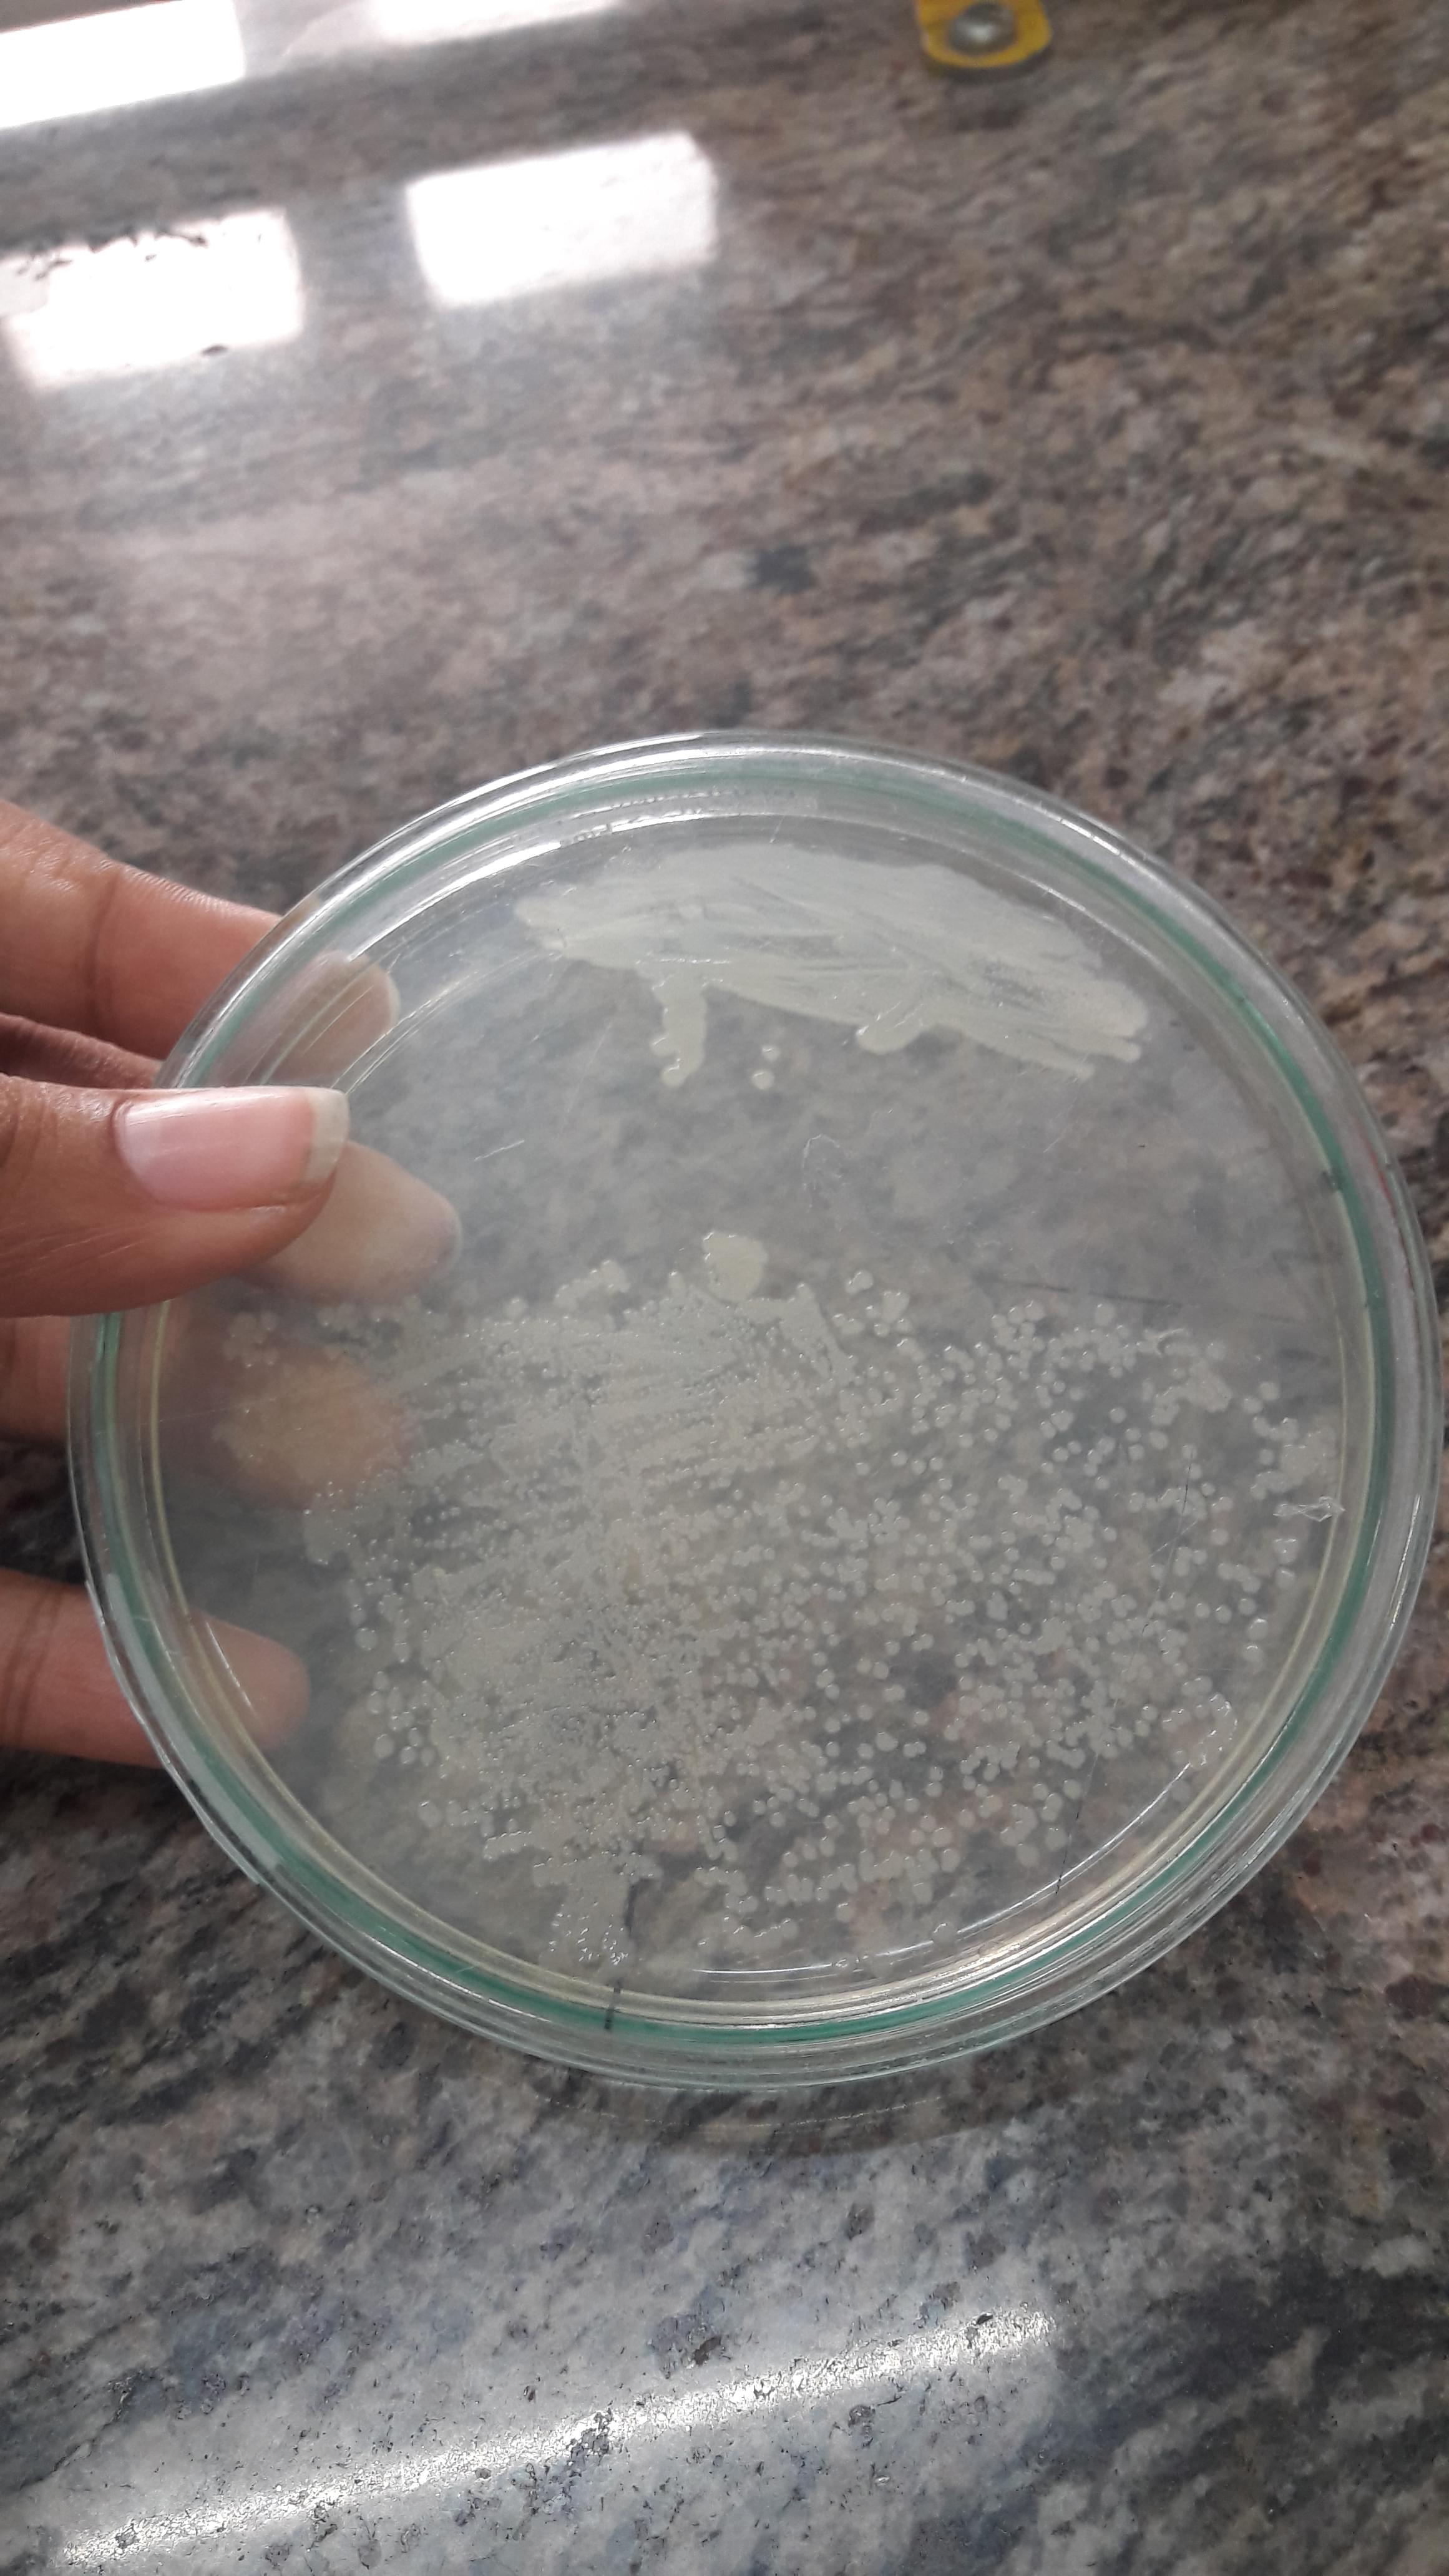

Kishinchand Chellaram College Mumbai Reviews on Placements, Faculty and Facilities
Why To Join Kishinchand Chellaram College Mumbai - Reviews & Rating



Most Popular Tags
Likes
- Faculty is very helpful and interactive.
- I like my cource and love the it is taught in classes.
- College have one of the best fest in the city.
Dislikes
- Campus is very small, no space to chill with friends.
- Should have a club house and a playground.
Course Curriculum Overview:
I choose this course because of my interest in filmmaking. And I got to know this is the best college for this course. Faculty is good and very supportive. Their teaching method is also very interactive.
0
0
Reply
Report
Anonymous
B.M.M
Reviewed on Dec 9, 2022(Enrolled 2022)Course Curriculum Overview:
I choose this course because I had to enter the media industry. The faculty of the college is decent the teachers are well experienced but the department doesn't work well very unorganized. There are end seems and internal tests held before end sems other than that there are SLEs and assignments for which you get marked.
0
0
Reply
Report
Student Snaps:

Placement Experience:
A placement cell is present. I am not sure about the placement rates for my course but many companies of high-end value are associated with our college which speaks volumes about the standards.
I hope to get placed as an intern with a stipend but my main aim is to start with my master's after graduating
0
0
Reply
Report
Course Curriculum Overview:
There are internal assessment tests, practicals, and finals per my opinion exams were pretty easy one can score a good percentage by honestly attending lectures daily and focusing on what has been taught.
0
0
Reply
Report
Vansh Vasdani
BMS, Marketing
Reviewed on Oct 17, 2022(Enrolled 2020)Placement Experience:
The placements are handled by the placement cell.
Students are eligible for placements from the 5th sem itself
Average package = 2.5 LPA Approx 50% of students appear for placements interviews out of which 15-20% take up the jobs
A big no for students who're traveling from another city in search of good knowledge and a Career
Boss, very gentle advice as a senior...you'll regret taking it up, throughout your course.
0
0
Reply
Report
Placement Experience:
There are good opportunities here. there is a nice selection ratio and an overall good median salary. Students are recruited by a variety of famous firms and almost all of them end up in one company or another. Many of the big corporate giants as well as foreign companies have tie-ups with KC College. campus interviews were conducted and the students were tested according to the company's requirements. There were various Companies like Free Press journal, The Print, KPMG India, TATA, Reliance, Infosys, OLA, Rajashree entertainment. Placement Coordinators can provide assistance if you have any questions or concerns. But Because of the Pandemic, things might be a little changed.
0
0
Reply
Report
Placement Experience:
Before the last semester, final exams placements are started and we can join any company if we get selected. For a fresher, the average salary per month is calculated between 15-20 thousand rupees. 70/80% of students opt for jobs and the remaining go for masters.
0
0
Reply
Report
Placement Experience:
Placements opportunity comes in plenty options here every student get a chance to join their loved/known company's and nearly 90% are placed also in those companies. Very few students remain unplaced and other students have their own family businesses so they decide to do that further in their life. So, there is no tension of remaining unemployed here. Companies like Tata, Infosys, Wipro, L&T, Philips, Cognizant and more come here to recruit students at the completion of this 3 years course. This companies offers a average packages during recruitments and they were like 2 - 3.5 LPA. And the highest package which was offered by philips was 7 - 8 LPA. In my batch only 2 students get lucky to get placed in Philips Company. And other students were placed in average packages which was 3 - 4.5 LPA. My plan after getting the degree was to be placed in product based companies like tcs or cognizant. And I did my best to get a job in tcs and I got the job from college. My package was 4 - 5 LPA.
0
0
Reply
Report
Placement Experience:
From the 6th semester, students get eligible for placement. Tcs, datamatics, Wipro, lti, pi technique and many other visited our college. I guess 70% of the students got the job in atleast one of the companies
0
0
Reply
Report
Placement Experience:
After Sem 4 students are eligible for placements.
Companies such as TCS, Wipro, Infosys, LTI and others visit colleges for placement.
Packages vary from company to company it starts from 3.5 L to 4.5/5 L.
Percentage of students getting placements are 40-50% . It totally depends on students who want to apply for jobs.
My plans are to doing masters in IT and do a job in one of the reputed companies. Also I have cleared aptitude round for Wipro company.
0
0
Reply
Report
Do you think the data is wrong ? Report Here
Kishinchand Chellaram College Mumbai Latest News
Mumbai: Final Year Online Exams 2020 Postponed, Due To Power Failure Across City, Check Details

Written ByCollegedunia Teamon Oct 12, 2020

Mumbai University Admission 2020: Second Merit List projects high cutoffs; Check MU Colleges closing scores

Written ByCollegedunia Teamon Aug 13, 2020

Mumbai University Admission 2020 Second Merit List (Released): St. Xavier's College, KC College, HR College 2nd Merit List, Check Here

Written ByCollegedunia Teamon Aug 11, 2020

Discover More Colleges






K J Somaiya College of Science and Commerce Mumbai
Ghatkopar East, Mumbai
4.1(68)
₹17825First year Fees







![Kishinchand Chellaram College - [KC College]](https://image-static.collegedunia.com/public/college_data/images/logos/1479367501KCC Logo glow final.jpg?h=71.7&w=71.7&mode=stretch)


























Comments